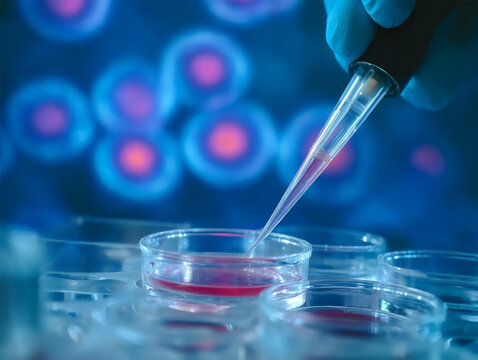

Adjuvant vs Neoadjuvant Systemic Therapy in Oncology
1. Definitions
| Term | Definition | Core Objective |
|——|————|—————-|
| Adjuvant Therapy | Systemic treatment delivered after definitive local therapy (surgery ± radiotherapy) | Eradicate occult micrometastatic disease to reduce recurrence & improve survival |
| Neoadjuvant Therapy | Systemic treatment given before planned definitive local therapy | Downstage tumor, enable resection/organ preservation, treat micrometastases early, assess in vivo sensitivity |
- 1. Definitions
- 2. Biological Rationale
- 3. Key Goals
- 4. Indications (Selected Examples)
- 5. Timing & Practical Considerations
- 6. Pathologic & Radiologic Response (Neoadjuvant)
- 7. Risk Stratification for Adjuvant Therapy
- 8. Advantages & Limitations
- 9. Decision Framework (Simplified)
- 10. Measuring Success
- 11. Emerging Trends
- 12. Practical Clinical Pearls
- 13. Key Takeaways
2. Biological Rationale
- Micrometastatic Dissemination: Tumor cell shedding can occur early, even when the primary seems localized.
- Growth Kinetics: Small-volume disease often contains a higher proliferative fraction and less clonal heterogeneity → greater chemosensitivity.
- Therapeutic Window: Early systemic intervention may prevent establishment of resistant macroscopic metastases.
3. Key Goals
| Dimension | Adjuvant | Neoadjuvant |
|———–|———|————-|
| Micrometastatic eradication | Primary goal | Concurrent goal |
| Tumor downstaging | Not applicable | Major objective (convert unresectable → resectable) |
| Margin optimization | Indirect (reduces late local relapse) | Improves chance of R0 resection |
| Organ preservation | Limited | Enables breast conservation, sphincter preservation, limb salvage |
| In vivo sensitivity data | Retrospective (through recurrence patterns) | Real-time assessment (pathologic response) |
| Early systemic control | Delayed until after recovery | Immediate |
4. Indications (Selected Examples)
| Cancer Type | Adjuvant Indications | Neoadjuvant Indications |
|————-|———————-|————————-|
| Breast | Node-positive, high-risk HR+, HER2+, TNBC | HER2+, TNBC (≥T2 or node+), locally advanced, inflammatory |
| Colorectal (Colon) | Stage III; high-risk Stage II | Rare (selected bulky T4 to facilitate resection) |
| Rectal | Post‑op chemo (Stage II/III) in some protocols | Standard (chemoradiotherapy ± total neoadjuvant therapy) for Stage II–III |
| Gastric | Post‑gastrectomy in select regions | Perioperative chemo (e.g., FLOT) for ≥T2 |
| Esophageal/GEJ | Post‑op adjuvant for residual disease (e.g., immunotherapy) | Neoadjuvant chemoradiation (cT2+ or node+) |
| NSCLC | Resected Stage II–III (adjuvant chemo ± targeted/IO) | Resectable Stage II–III (chemo ± immunotherapy) to increase pCR |
| Head & Neck (SCC) | High-risk post‑op (extranodal extension, positive margins) | Bulky, organ preservation protocols |
| Soft Tissue Sarcoma | High-risk features (size, grade) | Large high-grade extremity tumors (shrink for limb-sparing) |
| Pancreatic | Post‑resection (R0/R1) | Borderline resectable / locally advanced to enable R0 margin |
5. Timing & Practical Considerations
| Parameter | Adjuvant | Neoadjuvant |
|———–|———|————-|
| Initiation window | Typically within 4–8 weeks post‑op (wound healing dependent) | As soon as staging/biopsy completed (2–3 weeks) |
| Impact of delays | Prolonged delay (>8–12 wks) may reduce benefit | Delay risks local progression blocking surgery |
| Assessment metrics | Disease-free survival (DFS), overall survival (OS) | Pathologic complete response (pCR), radiographic downstaging, surgical margins |
| Regimen adjustment | Based on tolerance & pathology risk factors | Based on interim response, toxicity, biomarker shifts |
6. Pathologic & Radiologic Response (Neoadjuvant)
| Response Metric | Definition | Prognostic Significance |
|—————–|———–|————————|
| pCR | No residual invasive cancer in resected specimen (± nodes) | Associated with improved EFS/OS in TNBC, HER2+ breast |
| Major pathologic response (MPR) | ≤10% residual viable tumor (NSCLC) | Emerging surrogate endpoint |
| Tumor regression grade (TRG) | Histologic % of fibrosis vs viable tumor (GI, rectal) | Guides adjuvant strategy |
| Radiologic partial response | ≥30% reduction per RECIST | May not correlate perfectly with pCR |
7. Risk Stratification for Adjuvant Therapy
| Factor | High-Risk Indicators | Impact |
|——–|———————|——–|
| Pathologic stage | Node involvement, T3/T4 | Strong predictor of recurrence |
| Molecular features | HER2 amplification, high genomic risk score, MSI status | Alters regimen selection |
| Histologic grade | High grade / poor differentiation | Increases systemic relapse risk |
| Lymphovascular invasion | Present | Elevates recurrence probability |
8. Advantages & Limitations
| Aspect | Adjuvant Advantages | Adjuvant Limitations | Neoadjuvant Advantages | Neoadjuvant Limitations |
|——-|———————|———————-|————————|————————|
| Micrometastatic kill | Proven survival benefit (context dependent) | No in vivo sensitivity feedback | Treats early & assesses response | Risk of progression delaying surgery (rare with monitoring) |
| Surgical planning | Pathology fully known pre-systemic therapy | Larger surgery if tumor unreduced | Downstaging aids conservative surgery | Post-treatment fibrosis complicates pathology |
| Biomarker adaptation | Can tailor based on full pathology | Late adaptation | Early adaptation; dynamic change tracking | Some biomarkers (e.g., grade) may shift |
| Patient psychology | Surgery-first may reduce anxiety | Delayed systemic therapy start | Early systemic action reassuring | Anxiety due to untreated primary during therapy |
9. Decision Framework (Simplified)
- Comprehensive staging (imaging ± molecular profiling).
- Identify resectability and risk features (tumor size, nodes, margin feasibility).
- For borderline or locally advanced: favor neoadjuvant to improve operability and test sensitivity.
- For clearly resectable but high recurrence risk: proceed to surgery → adjuvant systemic therapy within optimal window.
- Integrate multidisciplinary tumor board input before sequencing decisions.
10. Measuring Success
| Setting | Primary Endpoints | Surrogate Endpoints |
|——–|——————|———————|
| Adjuvant | DFS, OS | ctDNA clearance (emerging), minimal residual disease markers |
| Neoadjuvant | pCR rate, event-free survival | MPR, early ctDNA kinetics |
11. Emerging Trends
| Trend | Description | Potential Impact |
|——-|————|——————|
| Total neoadjuvant therapy (TNT) | Consolidates systemic + chemoradiation pre-surgery (rectal cancer) | Higher pCR, optimized compliance |
| ctDNA-guided escalation/de-escalation | Post-op molecular residual disease detection | Tailors adjuvant intensity |
| Adaptive neoadjuvant modification | Mid-course switch in non-responders | Avoids ineffective exposure |
| Immunotherapy integration | Adding checkpoint blockade in early-stage high-risk disease | Improved pCR / EFS in select cancers |
| De-escalation after pCR | Omitting surgery or reducing adjuvant intensity (trials) | Organ preservation, reduced toxicity |
12. Practical Clinical Pearls
- Ensure adequate recovery (nutritional, wound) before adjuvant start; but avoid unnecessary delay.
- Document baseline tumor measurements and biomarkers before neoadjuvant therapy.
- Use standardized response criteria (RECIST, pCR definitions) for comparability.
- Multidisciplinary coordination is central—surgeon, medical, radiation oncology, pathology, radiology.
- Discuss fertility preservation when applicable prior to systemic initiation.
13. Key Takeaways
- Adjuvant therapy targets occult residual disease to reduce recurrence risk; timing and patient selection are critical.
- Neoadjuvant therapy offers tumor downstaging, early systemic control, organ preservation, and real-time biologic response data.
- Choice between strategies hinges on resectability, risk stratification, and potential for improved functional outcomes.
- Emerging molecular tools (ctDNA, genomic scores) are refining personalization of both approaches.
Disclaimer: Educational overview; apply within current guideline and patient-specific contexts.